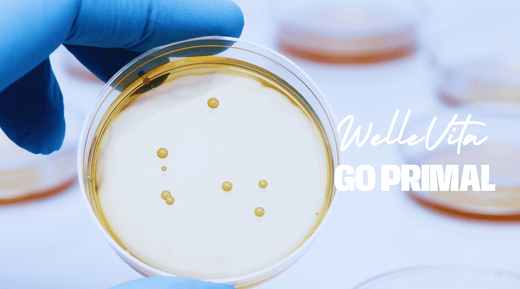

The Benefits of Lactobacillus Rhamnosus for Women: A Complete Guide to Health and Wellness
Share
Lactobacillus rhamnosus is a probiotic bacteria that is gaining popularity for its positive effects on women's health. Whether it's the Digestion , immune system, or even overall well-being, this powerful strain has a lot to offer. Women of all ages can benefit from the properties of Lactobacillus rhamnosus. But what makes this probiotic strain so unique, and how can you best incorporate it into your daily routine?
Bee WelleVita we believe in natural support for your health. Our Pro and Prebiotic Creamer Gutbiotic by GoPrimal is an easy way to harness the power of probiotics to use. With carefully chosen ingredients such as coconut milk powder, MCT oil, and 2 billion CFU (colony forming units) of various bacterial strains, it supports your intestinal flora and general health.
Read on to discover more about the specific benefits of Lactobacillus rhamnosus for women and how this probiotic can boost your well-being.
What is Lactobacillus Rhamnosus and Why is it Important?
🔬 What is Lactobacillus Rhamnosus? | 💡 Important to know! |
---|---|
A probiotic bacterial strain | Survives stomach acid effectively |
Natural resident of the intestines | Promotes a healthy microbiome |
Supports overall health | Helps to balance intestinal flora |
Lactobacillus rhamnosus is one of many probiotic bacteria that naturally occur in the gut. This strain is particularly hardy and has the ability to survive the acidic environment of the stomach and establish itself in the gut, where it can help maintain a healthy balance of good bacteria.
This probiotic bacteria has a range of benefits for women’s health. From supporting digestion and boosting the immune system to promoting emotional well-being, Lactobacillus rhamnosus is a versatile strain that can positively impact your overall health. But what are the specific benefits for women?
Specific Benefits of Lactobacillus Rhamnosus for Women
🟢 Advantage | 💁♀️ Relevance for Women |
---|---|
Improved digestion | Helps with a healthy bowel movement |
Strengthened immune system | Supports protection against pathogens |
Promoting emotional well-being | Supports mood and stress balance |
Supports skin health | Helps maintain healthy skin |
Vaginal health | Maintaining healthy flora |
1. Digestive support
Healthy digestion is essential for overall well-being. Lactobacillus rhamnosus can help to digestion to improve by keeping the intestinal flora in balance. This promotes the absorption of nutrients and reduces discomforts such as bloated feeling and gas. A clinical study shows that regularly consuming Lactobacillus rhamnosus can improve digestion【 https ://pubmed .ncbi .nlm .nih .gov /23249631/】 .
2. Strengthening the Immune System
Did you know that a large part of your immune system is located in your intestines? Lactobacillus rhamnosus supports immune function by promoting antibody production and maintaining a balance of good bacteria in the gut. According to research, this probiotic strain can increase immune response and help you feel fitter and more energetic【 https ://pubmed .ncbi .nlm .nih .gov /18602429/】 .
3. Skin Health and Shine
The benefits of Lactobacillus rhamnosus extend beyond the gut: it also has a positive effect on the skin. Research shows that probiotics can support healthy skin and help balance skin flora【 https ://pubmed .ncbi .nlm .nih .gov /29432779/】 . This can result in softer, smoother skin with a natural glow.
4. Emotional Balance and Wellbeing
Gut health is closely linked to the brain, and this is sometimes called the “gut-brain axis.” Lactobacillus rhamnosus can have a positive impact on mood and emotional balance, which can be especially helpful for women during different stages of life. One study suggests that this probiotic strain may contribute to better emotional stability【 https ://pubmed .ncbi .nlm .nih .gov /23474283/】 .
5. Vaginal Health
Lactobacillus rhamnosus can help maintain healthy vaginal flora. It can help maintain the natural balance of bacteria, which contributes to the overall comfort and well-being of women.
How Can You Include Lactobacillus Rhamnosus In Your Daily Routine?
🥣 Power source | 🍽️ Intake Method |
---|---|
Probiotic supplements | Capsules or powders to be taken |
Fermented foods | Yogurt, kefir, kimchi, kombucha |
Prebiotic fibers (such as inulin) | Daily supplementation through food |
1. Probiotic Supplements
Probiotic supplements with high concentrations of live bacteria are an effective way to boost your intestinal health to support. Choose a supplement that specifically Lactobacillus rhamnosus and that comes from a reliable brand such as GoPrimal .
2. Probiotic Foods
Foods like yogurt, kefir, kimchi, miso, and kombucha are rich in probiotics. By consuming these regularly, you can naturally support your gut flora and reap the benefits of Lactobacillus rhamnosus.
3. Prebiotics for Extra Support
Prebiotics are fibers that promote the growth of good bacteria. Think of foods like bananas, garlic, and oats, or opt for supplements with prebiotics such as inulin. The Pro and Prebiotic Creamer Gutbiotic by WelleVita contains a unique blend of prebiotics and probiotics for optimal support of intestinal health.
Frequently Asked Questions about Lactobacillus Rhamnosus
❓ Frequently Asked Question | 📝 Answer |
---|---|
What does Lactobacillus rhamnosus do for women? | Promotes intestinal health and immune system |
How quickly will I notice the effects? | Within a few days to weeks |
Can I combine it with other probiotics? | Yes, different strains can work synergistically |
Is it safe for children? | Yes, but consult a doctor for the correct dosage |
Does it help with a healthy weight? | May contribute to weight management |
1. What exactly does Lactobacillus rhamnosus do for women?
Lactobacillus rhamnosus promotes the balance of good bacteria in the intestines, supports digestion, strengthens the immune system and can have a positive effect on the emotional balance and skin health of women.
2. How quickly do you notice the effects of Lactobacillus rhamnosus?
Many people notice an improvement in their digestion and overall well-being within a few days to weeks of starting probiotics, but it varies from person to person and depends on factors such as diet and lifestyle.
3. Can I use Lactobacillus rhamnosus in combination with other probiotics?
Yes, combining different probiotic strains can actually be beneficial for the diversity of your intestinal flora . Products such as the Pro and Prebiotic Creamer Gutbiotic by WelleVita contain a mix of different strains for optimal support.
🏆 Benefit of Probiotic Mix | 📈 Why? |
---|---|
Synergy of different strains | Increases diversity of intestinal flora |
Combined benefits | Multiple positive effects on health |
Better microbiome support | Works effectively for digestion and immune system |
4. Can children also take Lactobacillus rhamnosus?
Yes, this probiotic strain is generally safe for children. Be sure to consult a pediatrician for advice on proper dosage and use.
5. How is Lactobacillus rhamnosus different from other probiotics?
Lactobacillus rhamnosus is unique in its ability to survive stomach acid and establish itself in the intestines, providing specific benefits for digestion, immune system, and overall health.
6. Can Lactobacillus rhamnosus help maintain a healthy weight?
While probiotics are not a miracle cure for weight management, research shows that Lactobacillus rhamnosus can contribute to a healthy metabolism and may aid in weight management when combined with a healthy diet and regular exercise【 https ://pubmed .ncbi .nlm .nih .gov /23963668/】 .
7. Can I use Lactobacillus rhamnosus during pregnancy?
This probiotic strain is generally considered safe for pregnant women, but it is always a good idea to consult your doctor before starting any new supplements during pregnancy.
Important Tips to Get the Most Out of Lactobacillus Rhamnosus
🌟 Tip | ✅ Action |
---|---|
Regular consumption | Take probiotics daily in |
Diversity in food | Eat probiotic and prebiotic foods |
Quality over quantity | Choose high-quality supplements |
- Regular Consumption : Take probiotics daily to reap maximum health benefits.
- Food Diversity : Eat a varied diet rich in fiber, probiotics and prebiotics to support gut health.
- Choosing Quality Products : Choose high-quality probiotics with a high CFU concentration of live bacteria, such as products from GoPrimal offered by WelleVita .
Conclusion: The Power of Lactobacillus Rhamnosus
Lactobacillus rhamnosus is a powerful probiotic bacteria that is specifically beneficial for women's health. From promoting healthy digestion and a strong immune system to supporting skin health and emotional balance, the benefits of this strain are numerous. By consuming probiotic foods and supplements, such as the Pro and Prebiotic Creamer Gutbiotic by By adding WelleVita to your daily routine, you can intestinal health improve and benefit from optimal health and well-being.
With this information, you are now ready to fully utilize the benefits of Lactobacillus rhamnosus for women and take your health to the next level!
Discover your Ideal Product with Our Health Test
Want to know which supplements best suit your specific health needs? Then take our health test! The Welle Vita test helps you find the ideal product that perfectly suits your lifestyle and goals. Visit our health test and receive personalized advice.